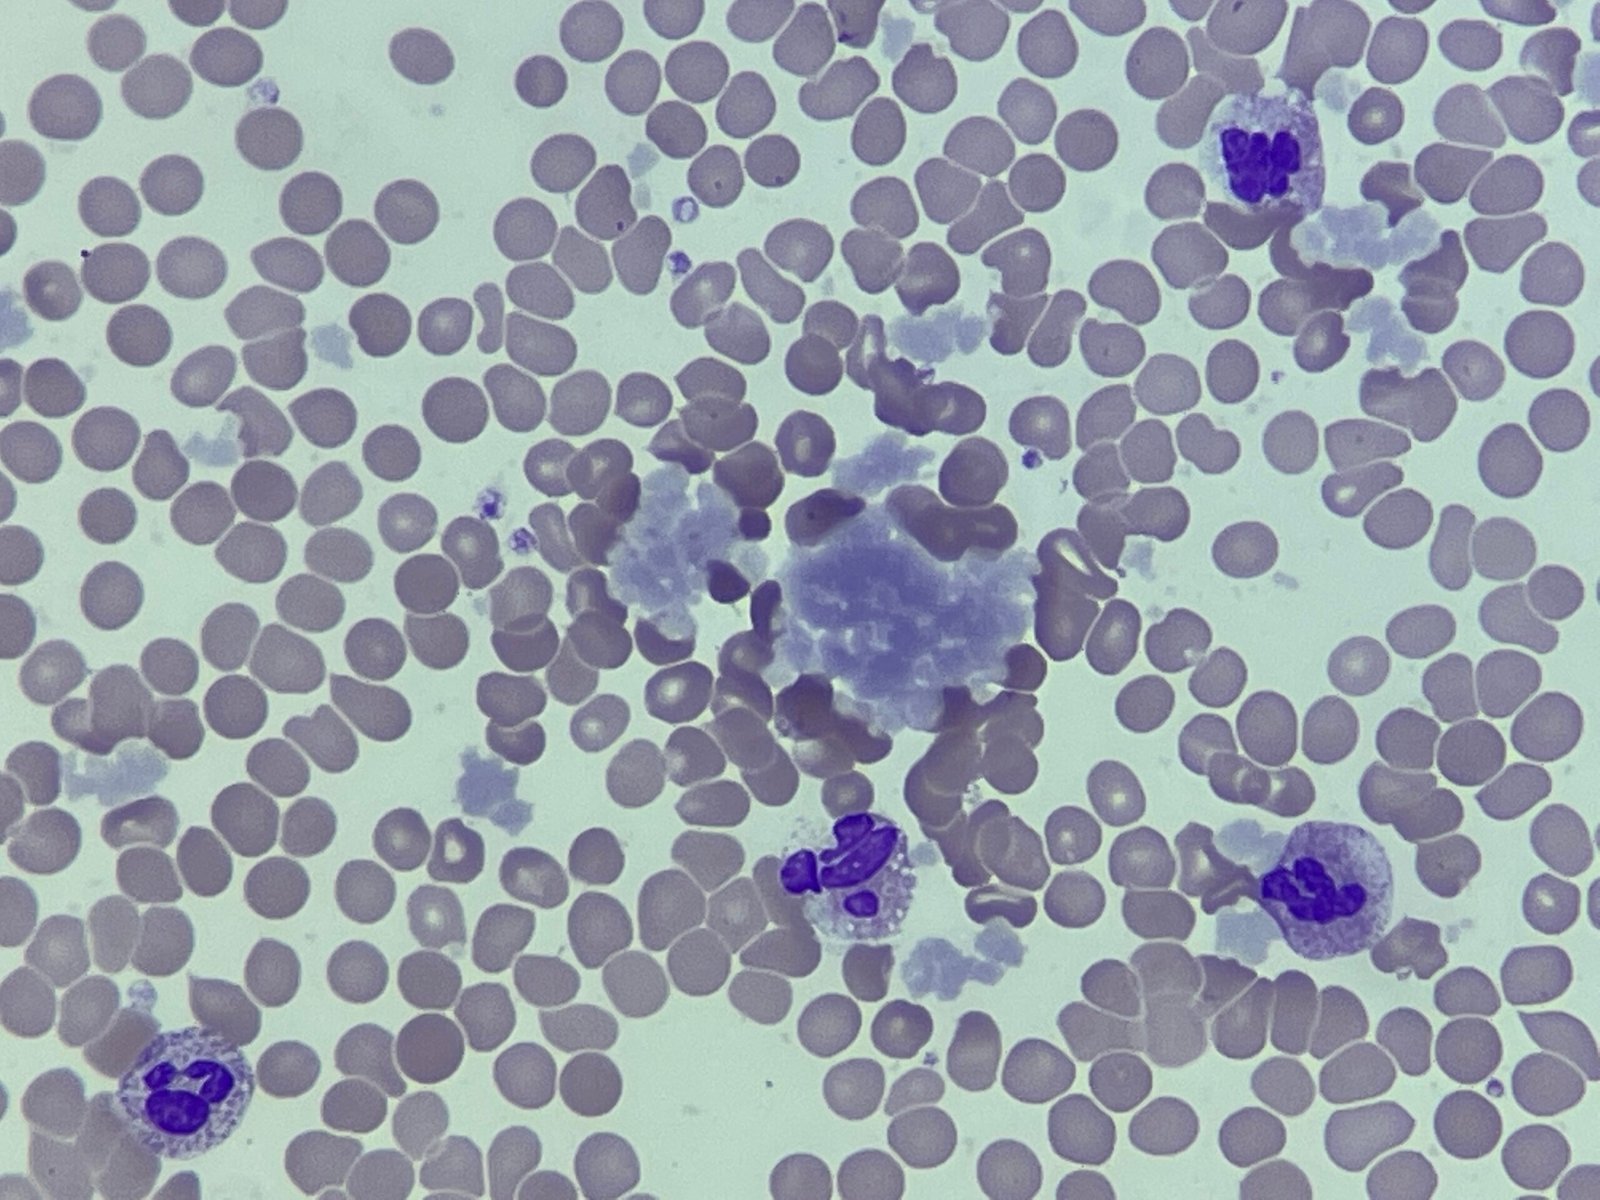

Cryoglobulins are abnormal antibodies (immunoglobulins) that precipitate or become insoluble at temperatures below normal body temperature (typically <37°C). In a peripheral blood film, as seen in the image, they can appear as amorphous, reddish-purple precipitates or clumps, often in the background or between cells.
Cryoglobulins occur in various conditions, most notably:
- Hepatitis C infection: A major cause.
- Other infections: Such as hepatitis B, HIV, and endocarditis.
- Autoimmune diseases: Like systemic lupus erythematosus (SLE), rheumatoid arthritis, and Sjögren’s syndrome.
- Lymphoproliferative disorders: Including multiple myeloma and Waldenström macroglobulinemia.
Their formation involves the cryoglobulins’ temperature-dependent aggregation. As blood cools (e.g., during transport or storage), these antibodies clump together, sometimes activating complement and causing inflammation. This precipitation can lead to symptoms like purpura, arthralgia, and neuropathy. In the lab, careful sample handling at 37°C is crucial to avoid artefactual cryoglobulin precipitation before testing.
_____
Image from personal photography
One Comment
Maybe cyroglobulin type 1